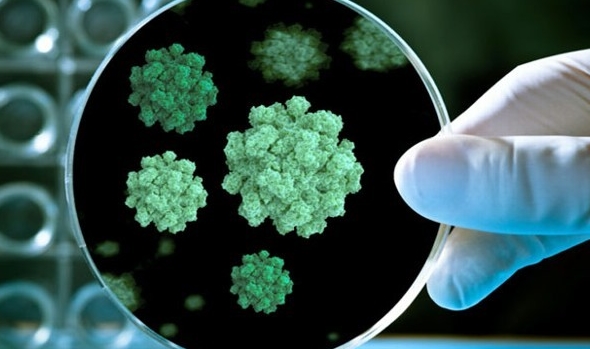

코로나19 재확산으로 ‘집콕 생활’은 일상이 되면서 집에 머무는 시간이 늘었습니다. 하지만 실내도 제대로 된 환기를 하지 않으면 건강에 위협이 될수 있습니다.


추운 날씨로 제대로 된 환기를 시키지 않으면 실내 공기가 원활하게 순환되지 않아 건강에 큰 지장을 초래할 수 있습니다. 겨울철에 특히 중요한 겨울철 실내 환기 요령에 대해 알아보겠습니다.
환기를 퉁해 바이러스 양 감소
코로나가 장기화 되면서 환기에 대한 중요성도 높아지고 있습니다. 올해 초 코로나19가 유행할 당시 방역 당국은 환기를 통해 실내 바이러스의 양을 크게 줄일 수 있다고 강조했습니다.


창문을 한 시간 열어 놓으면 전체 공기가 여섯 번 정도 완전히 교체됩니다. 다섯 번만 전체 공기가 환기되면 코로나 바이러스 양이 100분의 1 이하로 줄어든다고 합니다.


밀폐된 환경 바이러스 생존력 증가
코로나 바이러스는 밀폐된 환경에서는 바이러스의 생존력이 상당히 오래 가며 환기가 잘 이뤄질수록 바이러스에 노출될 가능성이 작아지는 것은 분명한 사실이라고 전문가가 밝히기도 했습니다.

그래서 소규모 음식점들은 물론이고, 자동 환기시설이 있는 다중이용시설이라도 주기적인 환기가 꼭 필요합니다.


겨울철 환기를 해야 하는 이유
요즘처럼 추워진 날씨에 찬바람이 싫다고 창문을 꼭꼭 닫아둔 채 생활하면, 실내 공기가 탁하고 건조해져 바이러스의 활동이 활발해지고 면역력은 떨어집니다. 특히 겨울철 실내에는 난방 열기와 먼지가 뒤섞여 오염물질이 많아집니다.


겨울엔 다른 계절보다 실내 공기 중 이산화탄소와 미세먼지, 라돈 농도가 짙어지므로 환기를 통해 실내에 정체돼 있는 오염된 공기를 바깥으로 내보내야 합니다.
효과적인 환기 방법
보통 환기는 오전, 오후, 저녁에 30분씩 하는 게 좋습니다. 환기를 자주 해야 실내공기가 청결해지고 호흡기 질환의 원인이 되는 곰팡이, 진드기 활동을 줄이는 효과도 있습니다.


가습기나 히터 사용시 1시간마다 환기 실내에서 가습기나 히터와 같은 난방기를 사용하고 있다면 1시간마다 5분 정도 환기하는 게 좋습니다. 이때 앞뒤 창문을 열어 맞바람 치게 하고 현관문까지 열어 두면 더욱 효과적이며 옷장이나 서랍 등 가구 문도 모두 열어두는 것이 좋습니다.


실내습도 조절 필수
겨울철 실내공기를 쾌적하게 관리하기 위해선 습도조절에도 신경을 써야 합니다. 겨울철에는 건조한 날씨가 이어져 실내습도가 낮아지기 쉽기 때문인데 낮은 실내습도는 호흡기 질환을 악화시키고 감기를 유발할 수 있습니다.


적정실내 습도 지키기
겨울철 실내 습도는 50~60% 정도를 유지하는 것이 적당한데, 가습기를 사용하거나 숯과 귤 껍질을 바구니에 담아 실내에 놓는 것도 도움이 됩니다. 또한 젖은 빨래를 널어놓는 것도 실내습도를 적당하게 유지하는데 좋습니다.


청소할때나 요리할때 창문열기
우리가 생활하는 집안에서 가장 많은 미세먼지가 발생하는 곳은 주방으로 음식의 재료를 굽거나 튀길때 많은 양의 미세먼지가 생기므로 요리할때는 창문을 열어놓는 것이 좋습니다.


주방에 창문이 없다면 공기청정기를 틀어 집안의 미세먼지를 잡아주고 숯이나 공기청정식물을 키우는 것도 도움이 됩니다.
'생활정보' 카테고리의 다른 글
| 신용평가 점수제 신용점수 관리방법 (0) | 2021.01.05 |
|---|---|
| 어도비 플래시 플레이어 윈도우 크롬 제거 방법 (0) | 2020.12.30 |
| 로또 인터넷 구매 방법 동행복권 (0) | 2020.12.29 |
| 코로나 2단계 패스트푸드점 포장과 배달만 가능 (0) | 2020.12.29 |
| 자동차 경고등 수도꼭지 엔진경고등 (0) | 2020.12.28 |
댓글